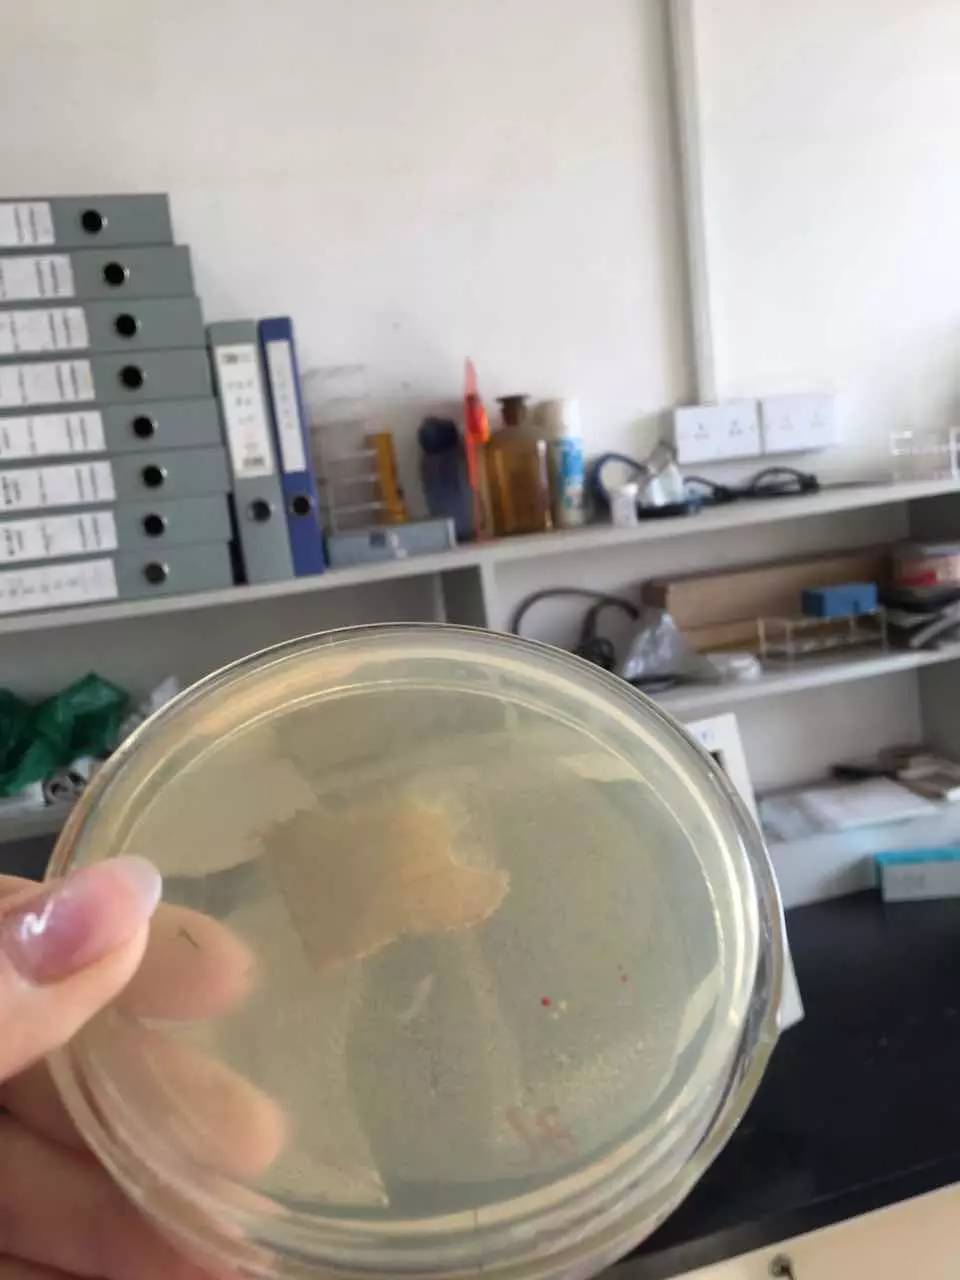

| 查看: 513 | 回复: 2 | |
kissyubo新虫 (初入文坛)
|
[求助]
转化后不表达 已有1人参与
|
![]() |
|
|
|
|
kaobo2012木虫 (正式写手)
|
|
|
2楼2016-03-27 16:47:11
|
|
kissyubo新虫 (初入文坛)
|
|
![]() |
|
|
3楼2016-03-28 21:24:19
|
|

回复此楼